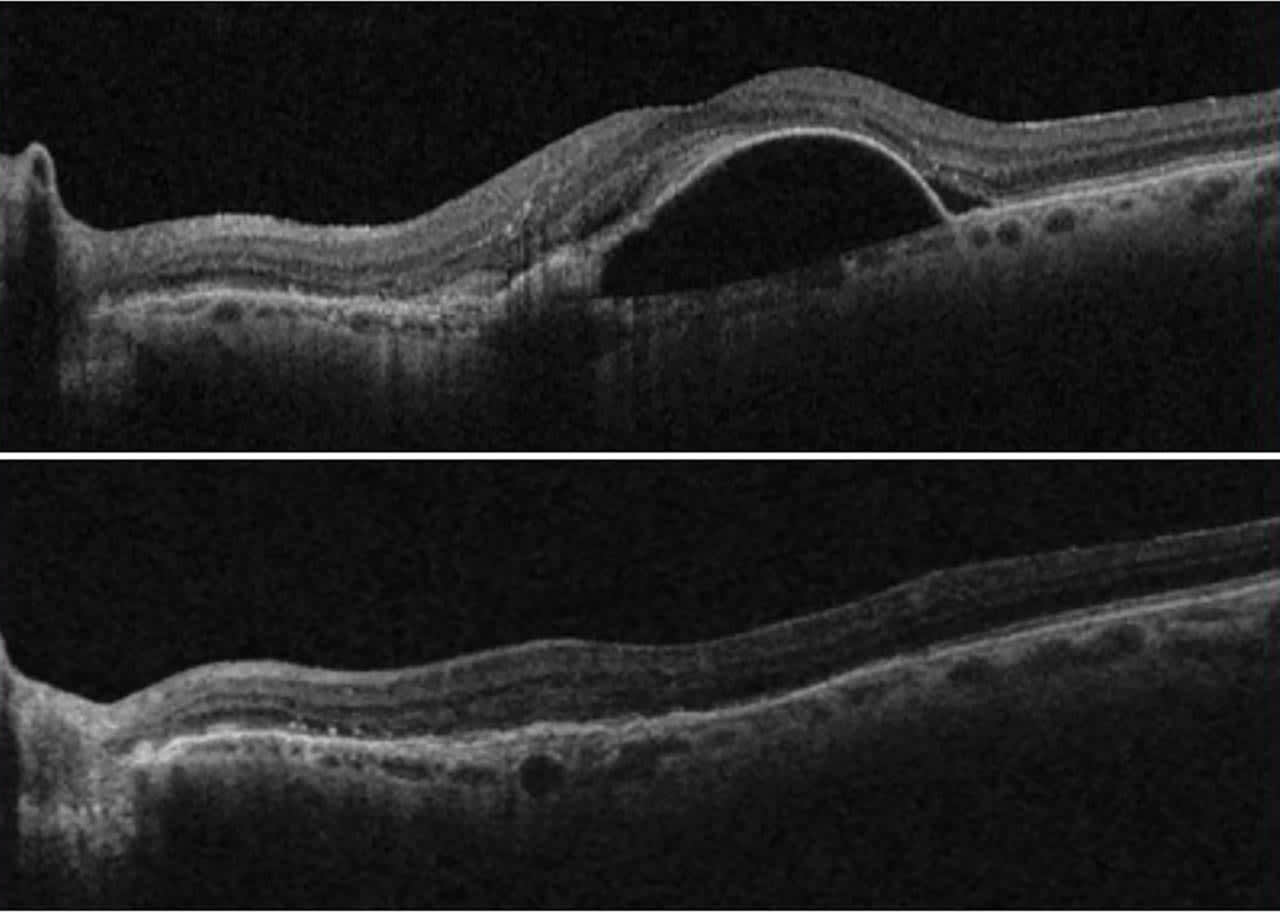

Neovascular age-related macular degeneration (nAMD), also called wet or exudative AMD, is a chronic, progressive disease of the central retina characterized by choroidal neovascularization (CNV). Vision loss from nAMD occurs through multiple mechanisms, including exudation, macular edema, fibrovascular scarring, and retinal pigment epithelium (RPE) tear or detachment.1 Vascular endothelial growth factor (VEGF) contributes to the pathogenesis of nAMD by promoting angiogenesis and vascular permeability.2 This is targeted by the current standard-of-care treatment for nAMD in the United States, which includes the anti-VEGF agents aflibercept (Eylea; Regeneron), bevacizumab (off-label Avastin; Genentech), brolucizumab (Beovu; Novartis), and ranibizumab (Lucentis; Genentech).3 All have been approved by the US Food and Drug Administration (FDA), as have biosimilars for aflibercept and ranibizumab.
Faricimab (Vabysmo; Genentech), the first bispecific monoclonal antibody targeting angiopoietin-2 (Ang2) in addition to VEGF, was approved by the FDA for the treatment of nAMD in 2022. Neutralization of Ang2 acts synergistically to stabilize the vascular endothelium and reduce exudation, and to reduce responsiveness to pro-angiogenic factors, including VEGF.4 Two identical, global phase 3 trials of faricimab (TENAYA and LUCERNE) including 1,329 treatment-naïve patients with nAMD demonstrated the safety and noninferiority of faricimab compared to aflibercept for the improvement of best-corrected visual acuity (BCVA).5 Whereas anti-VEGF treatment alone requires fixed-interval dosing every 8 weeks, faricimab has the potential advantage of extended durability, with nearly 80% of patients in TENAYA and LUCERNE achieving extension to at least 12-week dosing intervals or greater, and nearly 45% achieving extension to 16-week intervals.5
Based on the inclusion criteria for TENAYA and LUCERNE, 86% of treatment-naïve patients in a real-world nAMD population would be eligible for treatment.6 Real-world reports have additionally provided evidence for the efficacy of faricimab in eyes previously treated with other anti-VEGF agents.7-12
Figure 1. These optical coherence tomography (OCT) images of an 87-year-old female illustrate the impact of faricimab on pigment epithelial detachment (PED). The treatment-naïve patient presented with a large serous PED (A), which showed significant improvement after the first dose of faricimab (B). Images courtesy Nirojini Sivachandran, MD.
The purpose of this case series is to provide illustrative examples highlighting the real-world clinical versatility of faricimab beyond the applications studied in the original trials. We describe the successful use of faricimab in the treatment of nAMD-associated pigment epithelial detachment (PED), polypoidal choroidal vasculopathy (PCV), and peripheral exudative hemorrhagic chorioretinopathy (PEHCR) that extends into the macula (these treatments were considered on-label due to the involvement of hemorrhage in the macula).
Methods
A retrospective review of patients who presented with exaggerated features of nAMD between December 2022 and February 2024 was performed. Patients with nAMD-associated PED, PCV, or PEHCR who were treated with at least 1 dose of faricimab were included. Faricimab treatment followed standard protocols,5 including 3 loading doses of 6 mg at 4-week intervals, with further dosing protocol (treat and extend) dependent on disease activity assessments thereafter. Exclusion criteria included off-label use of faricimab, insufficient follow-up, or incomplete records.
The primary outcome was efficacy of faricimab as quantified by measures of central subfield thickness (CST), presence and height of PED, and BCVA. These were analyzed at baseline and following the first and third loading injections. CST, PED height, and type were determined from spectral domain optical coherence tomography (SD-OCT) images. Snellen visual acuities were converted to their logMAR equivalents, with count fingers being assigned 1.85.13 Secondary outcomes of adverse events during the study period were recorded. Patient demographics, including age, sex, and ethnicity, were also collected. Demographic characteristics were summarized using descriptive statistics. P-values for primary outcomes were calculated with the Wilcoxon signed-rank test. Analyses were performed in Excel and R.
Results
A total of 16 eyes from 15 patients with nAMD with remarkable features treated with faricimab were included (Table 1). Of these, 6 eyes had PED, 5 had PCV, 4 had notable treatment durability, and 1 had PEHCR. Mean follow-up time was 1 year. Of these 16 eyes, 11 were treatment naïve. Average age was 77.3±2.2 years, 75% of patients were female, and 75% were White. Average visual acuity at baseline was 0.88±0.11 (≈20/152), CST was 377±36µm, and PED height was 416±71µm. Where present, 5 of 12 PEDs were fibrovascular, with remaining being serous (4) or mixed (3).

Table 1: Demographics and Treatment Regimen
PED, pigment epithelial detachment; nAMD, neovascular age-related macular degeneration; PCV, polypoidal choroidal vasculopathy; PEHCR, peripheral exudative hemorrhagic chorioretinopathy; OD, right eye; OS, left eye.
At first follow-up after a single dose of faricimab (Table 2), average BCVA significantly improved to 0.56±0.08 (≈20/73; P=.0013). There was a significant reduction of 130 µm in CST, to 247±11 µm (P=.00012), and a reduction of 219 µm in PED height to 197±35 µm (P=.0015). After 3 loading doses of faricimab, vision improvements from baseline were maintained, with average BCVA at follow-up of 0.59±0.11 (≈20/78), P=.0039 change from baseline. Ongoing improvements in CST and PED height were observed, with average CST 216±14 µm (a reduction of 161 µm from baseline; P=.0039), and average PED height of 168±40 µm (a reduction of 248 µm from baseline; P=.0117). No adverse events occurred, including anterior or posterior segment inflammation, retinal vasculitis, or endophthalmitis. Average treatment interval at the end of the study period was 11.8 weeks, compared to an average of 5.6 weeks on previous anti-VEGF agents in switch patients, a 2-fold increase.

Table 2: Outcomes of Faricimab Treatment
BCVA, best-corrected visual acuity; CST, central subfield thickness; PED, pigment epithelial detachment.
Illustrative Example Cases
Case 4 illustrates the effect of faricimab on PED. An 87-year-old White female was referred for decreased vision in the left eye for 3 months. Her vision at presentation was 20/20 in the right and 20/100 in the left eye and she endorsed significant metamorphopsia in the left eye. On exam, the left eye had subretinal hyperreflective material (SHRM), subretinal fluid (SRF), and a large serous PED (Figure 1). The patient elected to undergo treatment with faricimab. During her first follow-up visit, she noted marked improvement in metamorphopsia. Her vision improved to 20/50 in the left eye, a reduction in PED height was noted from 504 µm to 134 µm, and CST improved from 346 µm to 305 µm. After 3 loading doses, her vision continued to improve to 20/25 in the left eye. She has been able to maintain stability with an injection interval every 6 to 8 weeks.
Case 8 illustrates the effect of faricimab in PCV treatment. In this case, a 57-year-old East Asian male, with a history of smoking, reported decreased vision over 6 months in his right eye. On examination his vision was 20/250, with macular hemorrhage and exudate. OCT showed peaked PED with double layer sign, intraretinal fluid (IRF), SRF, and SHRM (Figure 2). With a single faricimab treatment, the patient’s CST improved from 401 µm to 254 µm, and PED height reduced from 337 µm to 272 µm. The patient’s vision improved to 20/200 after a single treatment, 20/100 after loading, and was 20/40 at last visit 28 weeks after the last treatment.

Figure 2. A 57-year-old East Asian male presented with macular hemorrhage and exudate in the right eye. Optical coherence tomography (OCT) showed a peaked pigment epithelial detachment, pachyvessels in the choroid, intraretinal and subretinal fluid, and subretinal hyperreflective material (A). These resolved after extension to 7 doses (B, 1 dose; C, 3 doses; D, 7 doses). The hemorrhage and exudate was noted on fundus photos before treatment (E) and resolution is shown after 3 faricimab doses (F). Images courtesy Nirojini Sivachandran, MD.
The unanticipated durability of faricimab is illustrated by case 15, an 82-year-old White female who presented with nAMD in her left eye. Her vision was 20/50 in this eye, and she elected to undergo anti-VEGF treatment with aflibercept. After 3 loading doses, she was noted to have subtle SRF with vision improvement to 20/30 and was advised to follow up in 1 month. However, she missed several appointments. When she presented to the clinic 16 weeks later, examination found a substantial increase in SRF and decreased vision to 20/50 (Figure 3). At this point, the agent was switched to faricimab, and the patient was counselled on the importance of follow-up. The patient again missed multiple appointments, presenting to clinic 16 weeks later. Her vision in the left eye had improved to 20/40, she had trace SRF, and her CST had improved from 285 µm to 215 µm, a decrease of 70 µm.

Figure 3. An 82-year-old female received 4 doses of aflibercept in the left eye and self-extended herself to 16 weeks, then presented with significant subretinal fluid (A). A single treatment of faricimab lead to rapid suppression of subretinal fluid (B), which was sustained following another self-extension to 16 weeks. Images courtesy Nirojini Sivachandran, MD.
Case 16 illustrates the rapid improvement in PEHCR-associated exudation with faricimab. In this case, a 93-year-old White male was assessed for temporal retinal hemorrhage in the left eye. He was diagnosed with PEHCR. The patient elected not to undergo treatment, as this was not visually significant (20/50 OU) and he was functioning well. Four months later, the patient presented with counting fingers vision in the left eye with massive SRF from a temporal exudative process and subretinal hemorrhage extending into the macula. At this point, he elected to undergo treatment with faricimab. At first follow-up, there was marked reduction in SRF and CST (686 µm to 315 µm), and the patient’s vision improved to 20/150. After 3 doses, his vision improved to 20/100 and the macular hemorrhage nearly resolved in the left eye. At this visit the patient was noted to have substantial subretinal hemorrhage involving the posterior pole of the right eye and he elected to undergo bilateral treatment with faricimab. This hemorrhage has improved with treatment (2 doses OD, 5 doses OS).
Discussion
These cases illustrate the clinical versatility of faricimab in its early use in the real-world setting of a large retina-only practice, describing cases not represented in nAMD clinical trials for faricimab or existing reports. Treatment with faricimab in nAMD-associated PED, PCV, and PEHCR consistently resulted in a rapid and sustained reduction in CST and improvement in vision. These cases highlight the synergistic benefit of anti-VEGF and anti-Ang2 action in reducing neovascularization and stabilizing existing vasculature to reduce exudation. There was no anterior or posterior segment inflammation, retinal vasculitis, endophthalmitis, or other adverse events.
Given the role of Ang2 in fluid exudation, faricimab is a particularly promising treatment for patients with a high fluid burden. In patients with nAMD-associated PED, we found faricimab rapidly improved PED height (by an average of 218 µm) and vision (from ≈20/152 to ≈20/73) after a single injection. Moreover, there were no adverse events related to PED, such as RPE tear. This is consistent with other reports of PED resolution in treatment-naïve and switch patients,8,9,12 with 1 study finding resolution of PED after single injection of faricimab in 42% (7/19) of treatment-naïve patients.8
The role of faricimab in PCV in the real-world setting has not been well explored. We present 4 cases of PCV (as defined by clinical and OCT features) with good response to faricimab. All 4 cases additionally had macular hemorrhage, which resolved with treatment. We observed significant reductions in PED height and improved visual acuity following 3 doses of faricimab, with initial reductions in SRF and improvements in BCVA after a single dose. This is supported by 1 previously reported case of a treatment-naïve 71-year-old female who experienced resolution of SRF and PED after a single faricimab injection.9 Notably, the case of PCV highlighted here had durability of resolution, with extension to 28 weeks after last treatment with faricimab. This is, to our knowledge, the longest treatment durability reported to date with faricimab.
In an environment of multiple highly efficacious approved agents for the treatment of nAMD, faricimab stands out for its the durability of treatment response. In clinical trials, nearly 45% of patients were extended successfully to 16-week treatment intervals5 with comparable outcomes to aflibercept at 8-week intervals, and year 2 data increases this proportion to 60% of patients.8 We present a notable case of a patient with difficult follow-up who served as her own control; she returned with worsened SRF and visual acuity 16 weeks after 3 loading doses of aflibercept, then after a single dose of faricimab, she was again lost to follow-up for 16 weeks, but impressively returned with only trace SRF and improved vision. This unusual case exemplifies the synergistic benefit of anti-VEGF and anti-Ang2 activity for the effective, durable treatment of nAMD. An additional 3 cases confirm the real-world durability of full treatment with faricimab in nAMD. The average treatment interval for faricimab from all cases was approximately double that of prior anti-VEGF treatment needs in switch patients at 11.8 weeks. Faricimab may therefore alleviate treatment burden for patients and the healthcare system.
Finally, the case of PEHCR represents the first reported use of faricimab in the treatment of this condition. PEHCR is a rare degenerative condition, considered by some to be a variant of AMD,14 in that it resembles nAMD of the peripheral retina. While often asymptomatic or minimally impactful on vision, PEHCR becomes symptomatic as in the present case when peripheral lesions extend to involve the macula. In these cases, a previous report found variable benefit of anti-VEGF treatment to reduce macular subretinal fluid and improve vision.15 In the present case, faricimab rapidly improved exudation and hemorrhage, resulting in improved vision. Studies investigating the best agent for PEHCR are warranted.
This clinical case series has several limitations, the first being that it is a noncomparative case series. While this is a first step in the clinical investigation of a new treatment,16,17 the present study is further limited by sample size. It is underpowered to detect effectiveness within specific diagnostic groups and cannot be used to infer equivalence to existing treatments. Together, these cases provide real-world pilot data on the clinical versatility of faricimab toward future investigations of its efficacy in these clinical contexts. This case series provides early evidence suggesting multiple clinical applications in which the use of faricimab may be advantageous. Treatment response was rapid and durable after even a single treatment, with good efficacy for fluid reduction and visual improvements in nAMD with PED, PCV, and PEHCR. Future work is needed to clarify the efficacy of faricimab as compared to other anti-VEGF agents in similar clinical cases not sufficiently explored in phase 3 trials. NRP
References
1. Wong T, Chakravarthy U, Klein R, et al. The natural history and prognosis of neovascular age-related macular degeneration: a systematic review of the literature and meta-analysis. Ophthalmology. 2008;115(1):116-126.e1. doi:10.1016/j.ophtha.2007.03.008
2. Kovach JL, Schwartz SG, Flynn HW, Scott IU. Anti-VEGF treatment strategies for wet AMD. J Ophthalmol. 2012;2012:e786870. doi:10.1155/2012/786870
3. Ye L, Jiaqi Z, Jianchao W, Zhaohui F, Liang Y, Xiaohui Z. Comparative efficacy and safety of anti-vascular endothelial growth factor regimens for neovascular age-related macular degeneration: systematic review and Bayesian network meta-analysis. Ther Adv Chronic Dis. 2020;11:2040622320953349. doi:10.1177/2040622320953349
4. Chakravarthy U, Bailey C, Brown D, et al. Phase 1 trial of anti–vascular endothelial growth factor/anti-angiopoietin 2 bispecific antibody RG7716 for neovascular age-related macular degeneration. Ophthalmol Retina. 2017;1(6):474-485. doi:10.1016/j.oret.2017.03.003
5. Heier JS, Khanani AM, Quezada Ruiz C, et al. Efficacy, durability, and safety of intravitreal faricimab up to every 16 weeks for neovascular age-related macular degeneration (TENAYA and LUCERNE): two randomised, double-masked, phase 3, non-inferiority trials. The Lancet. 2022;399(10326):729-740. doi:10.1016/S0140-6736(22)00010-1
6. Jern I, Forsell S, Norberg H. Eligibility for faricimab in a real-world neovascular age-related macular degeneration population: a cross-sectional study. BMJ Open. 2022;12(9):e065001. doi:10.1136/bmjopen-2022-065001
7. Leung EH, Oh DJ, Alderson SE, et al. Initial real-world experience with faricimab in treatment-resistant neovascular age-related macular degeneration. Clin Ophthalmol. 2023;17:1287-1293. doi:10.2147/OPTH.S409822
8. Khanani AM, Aziz AA, Khan H, et al. The real-world efficacy and safety of faricimab in neovascular age-related macular degeneration: the TRUCKEE study — 6 month results. Eye (Lond). 2023;37(17):3574-3581. doi:10.1038/s41433-023-02553-5
9. Stanga PE, Valentín-Bravo FJ, Stanga SEF, Reinstein UI, Pastor-Idoate S, Downes SM. Faricimab in neovascular AMD: first report of real-world outcomes in an independent retina clinic. Eye (Lond). 2023;37(15):3282-3289. doi:10.1038/s41433-023-02505-z
10. Ng B, Kolli H, Ajith Kumar N, et al. Real-world data on faricimab switching in treatment-refractory neovascular age-related macular degeneration. Life. 2024;14(2):193. doi:10.3390/life14020193
11. Grimaldi G, Cancian G, Rizzato A, et al. Intravitreal faricimab for neovascular age-related macular degeneration previously treated with traditional anti-VEGF compounds: a real-world prospective study. Graefes Arch Clin Exp Ophthalmol. 2024;262(4):1151-1159. doi:10.1007/s00417-023-06319-3
12. Szigiato A, Mohan N, Talcott KE, et al. Short-term outcomes of faricimab in patients with neovascular age-related macular degeneration on prior anti-VEGF therapy. Ophthalmol Retina. 2024;8(1):10-17. doi:10.1016/j.oret.2023.08.018
13. Lange C, Feltgen N, Junker B, Schulze-Bonsel K, Bach M. Resolving the clinical acuity categories “hand motion” and “counting fingers” using the Freiburg Visual Acuity Test (FrACT). Graefes Arch Clin Exp Ophthalmol. 2009;247(1):137-142. doi:10.1007/s00417-008-0926-0
14. Shroff D, Sharma M, Chhablani J, Gupta P, Gupta C, Shroff C. Peripheral exudative hemorrhagic chorioretinopathy — a new addition to the spectrum of pachychoroid disease? Retina. 2021;41(7):1518. doi:10.1097/IAE.0000000000003063
15. Seibel I, Hager A, Duncker T, et al. Anti-VEGF therapy in symptomatic peripheral exudative hemorrhagic chorioretinopathy (PEHCR) involving the macula. Graefes Arch Clin Exp Ophthalmol. 2016;254(4):653-659. doi:10.1007/s00417-015-3096-x
16. Kempen JH. Appropriate use and reporting of uncontrolled case series in the medical literature. Am J Ophthalmol. 2011;151(1):7-10.e1. doi:10.1016/j.ajo.2010.08.047
17. Jabs DA. Improving the reporting of clinical case series. Am J Ophthalmol. 2005;139(5):900-905. doi:10.1016/j.ajo.2004.12.009








